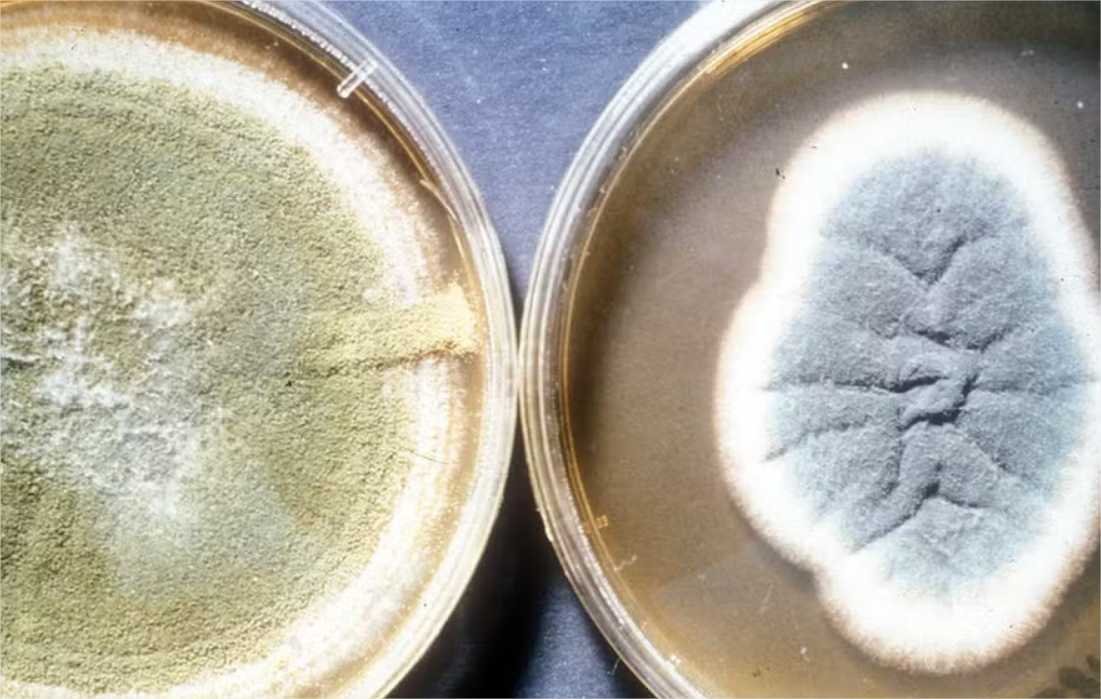
Fungo achado em tumba de faraó se torna novo (e potente) composto anticâncer

Fungo achado em tumba de faraó se torna novo (e potente) composto anticâncer
Um total de 3,75 milhões de pessoas morrem por doenças causadas por fungos no mundo. Mesmo que apenas uma pequena porcentagem dos fungos seja venenosa (2%), essas espécies podem causar diversos problemas para a saúde humana. Porém, engenheiros da Universidade da Pensilvânia encontraram uma forma de usá-los para salvarem vidas.
Os pesquisadores isolaram uma nova classe de moléculas do fungo Aspergillus flavus, modificando os seus compostos químicos e os testando contra células de leucemia. Os resultados apresentaram uma reação anticancerígena que se equipara a de medicamentos regulados pela FDA (Food and Drug Administration), equivalente à Anvisa nos EUA.
De venenoso para terapêutico
O Aspergillus flavus já possui a fama de ser letal e um histórico de contaminar plantações e de causar mortes após seu contato com escavações antigas. Quando a tumba do faraó Tutancâmon foi descoberta na década de 1920, vários membros da equipe de escavação tiveram mortes prematuras após a abertura do sarcófago. Contrariando a teoria de uma possível maldição do faraó, a explicação levantada poderia ser a presença de esporos fúngicos que estavam antes adormecidos na tumba.
/i.s3.glbimg.com/v1/AUTH_fde5cd494fb04473a83fa5fd57ad4542/internal_photos/bs/2025/u/5/iB1AJBRseOQzucuv9l5A/960px-aspergillus-flavus.jpg)
O A. flavus, cujas toxinas podem causar infecções pulmonares, já foi encontrado em escavações desse tipo. Agora, ele pode ser um recurso importante na elaboração de terapias alternativas contra o câncer.
Seleção de gene
O tratamento desenvolvido na pesquisa, publicada na revista científica Nature Chemical Biology, envolveu a modificação genética de peptídeos — um tipo de molécula essencial na construção de proteínas. Poucos fungos são capazes de produzir essas moléculas na forma de uma purificação natural, fazendo com que composto final produzido tenha, de fato, maiores propriedades anticancerígenas.
Após decidirem que o A. flavus seria um promissor candidato de estudo, os pesquisadores fizeram experimentos para encontrar a proteína de origem dos peptídeos especiais. Usando marcadores químicos que indicam a presença dessas moléculas, eles identificaram os genes responsáveis por essa produção proteica específica no fungo.
A descoberta também revelou que essas moléculas do A. flavus compartilham uma estrutura única formada por anéis interligados. Em comunicado, também foi descrito que elas apresentaram efeitos potentes de supressão de células sanguíneas cancerosas da medula óssea, substituindo células saudáveis e prejudicando a função normal do sangue (o que conhecemos como leucemia).
/i.s3.glbimg.com/v1/AUTH_fde5cd494fb04473a83fa5fd57ad4542/internal_photos/bs/2025/I/T/645SBgSleQGmMmB226sg/low-res-gao-lab-fungal-ripps-12.jpg)
Acesso VIP
Outro experimento no qual os pesquisadores adicionaram um lipídio — molécula normalmente associada às gorduras — fez com que os peptídeos especiais gerassem um desempenho equivalente ao da citarabina e daunorrubicina, ambos medicamentos aprovados pela FDA e que vêm sendo usados há décadas para o tratamento de leucemia.
Ativando e desativando genes presentes nas células de leucemia, cientistas notaram que um deles era fundamental para permitir que os peptídeos entrassem nas células cancerígenas em quantidade suficiente. A teoria para explicar o porquê dos lipídios serem efetivos nesse processo seria, justamente, a influência na expressão desse gene.
“Saber que os lipídios podem influenciar como esse gene transporta compostos para dentro das células nos dá mais uma ferramenta para o desenvolvimento de medicamentos”, diz Qiuyue Nie.
Testes futuros envolvendo a substância envolvem simular qual é o efeito dessas estruturas em animais para que, futuramente, os avanços possam ser aplicados em estudos clínicos em humanos.
(Por Fernanda Zibordi)






